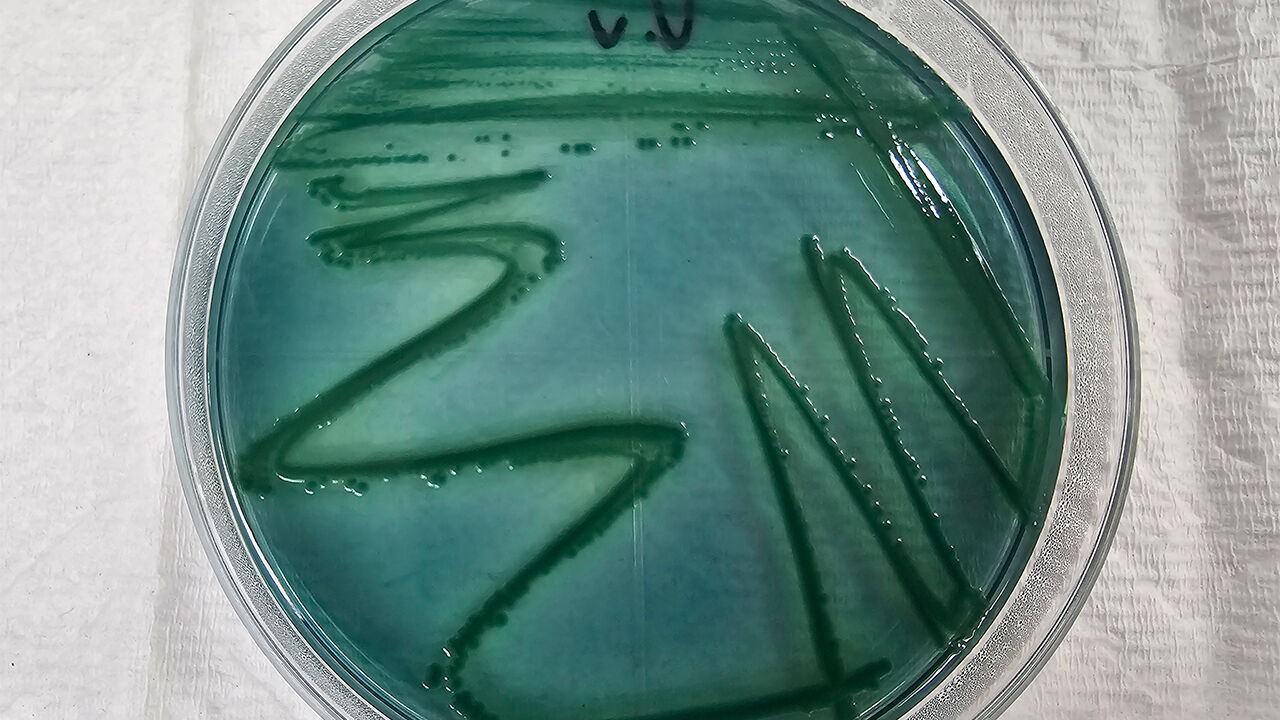

▲ 비브리오패혈증균
인천 앞바다에서 올해 첫 비브리오패혈증균이 검출됐습니다.
인천광역시 보건환경연구원은 지난 27일 인천 연안의 해수를 분석한 결과 비브리오패혈증균이 올해 처음으로 검출됐다고 밝혔습니다.
비브리오패혈증균은 겨울철 해저 갯벌에서 월동하다가 해수 온도가 18℃ 이상으로 오르는 봄철부터 바다 표면에서 본격적으로 검출됩니다.
오염된 어패류를 날로 섭취하거나 상처 난 피부가 오염된 해수에 접촉할 경우 감염될 수 있고 사람 간 전파는 이뤄지지 않습니다.
주요 증상은 최대 72시간의 잠복기를 거쳐 급성 발열과 오한, 복통, 설사 등이 나타나고 발열 후 24시간 이내에 주로 하지에서 발진, 부종이 발생해 수포나 출혈성 물집으로 진행될 수 있습니다.
특히 간경화·간암 등 만성 간 질환자와 당뇨병 환자 등 고위험군이 감염되면 치명률이 약 50%에 달해 각별한 주의가 요구됩니다.
예방을 위해서는 어패류는 흐르는 수돗물에 깨끗이 세척하는 등 위생 수칙을 준수하고 85℃ 이상으로 충분히 가열해 먹어야 합니다.
상처가 있는 경우 바닷물과의 접촉을 자제하고 도마와 칼 등 조리 기구는 철저히 소독해야 합니다.
(사진=연합뉴스)

동영상 기사
동영상 기사


 동영상 기사
동영상 기사

댓글